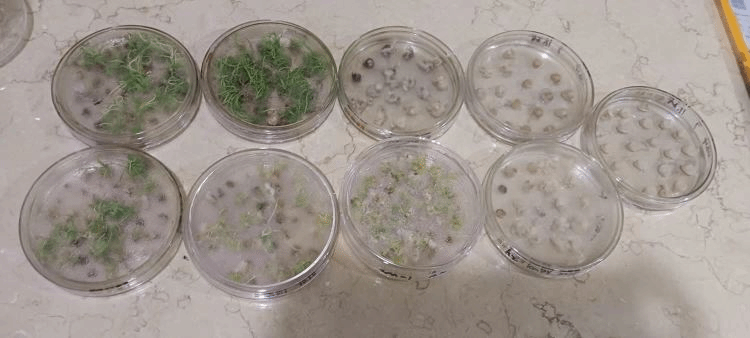

2023年12月4日,2021生物科学班第一天专业见习如期在中国热带农业科学院热带生物技术研究所展开,今天见习的带队老师有冯志国老师和林惠娇老师。生物所的授课老师有冯翠莲老师、羊以武老师以及讲解员潘雨辰老师。


上午9:00,同学们到达热科院生物所后,由羊老师首先为同学们介绍热科院研究所的基本情况和组成部分,让同学们对热科院各研究所有初步的了解。

9:30,由讲解员潘雨辰老师带领我们开始专业见习。

首先同学们来到了植物园,由潘老师讲解了许多植物的经济价值、药用价值以及许多有趣的知识。







我们依次参观了海洋馆、南药馆、生态馆、品种资源馆、橡胶馆、生物所展览馆以及中国热科院展览馆。











11:30,潘老师带领同学们参观了中国热科院展览馆,上午的行程就暂时告一段落了。
下午3:00,同学们开始进行见习的重要环节,植物克隆技术——甘蔗组织培养。


冯翠莲老师首先为同学们讲解了植物组织培养所需的材料、设备、生长条件、实验步骤及培养过程中出现的问题和解决方法。





接下来,冯老师带领同学们开始了模拟实验操作。



首先同学们进行实验前的培养材料准备。然后开始进行外植体清洗、消毒以及切片训练。





经过老师的讲解和视频演示,同学们掌握了组织切片和接种操作,实践能力得到了冯老师的肯定。

经过第一天的实习让同学们见识到了各种各样的植物以及动物,学习到了丰富的专业知识。此外,同学们还学习到了“儋州立业,宝岛生根”的两院精神。此次见习不仅夯实了专业基础,拓宽了同学们的专业视野,而且还激励着同学们不断勇攀科学高峰。